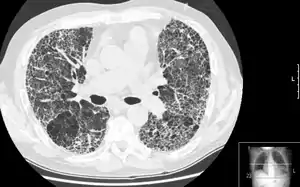

Компьютерная томография высокого разрешения
Компьютерная томография высокого разрешения (КТВР) лёгких — медицинское исследование, применяемое для диагностики и оценки интерстициальных заболеваний лёгких. Метод использует специальные параметры КТ-сканирования, позволяющие оценить состояние лёгочной ткани.
Технические аспекты
КТВР производится обычным КТ-сканером. Для получения изображения используются параметры сканирования, позволяющие максимизировать пространственное разрешение:
- тонкие срезы (обычно 1-2 мм)
- алгоритм реконструкции изображений с высоким пространственным разрешением
- минимальный FOV (поле зрения), для минимизации размеров каждого пикселя
- другие параметры сканирования, способствующие увеличению его скорости
В зависимости от предполагаемого диагноза, исследование может проводиться на вдохе и выдохе, в положении лёжа на спине или животе.
Поскольку КТВР применяется для оценки диффузных изменений легочной ткани, зона сканирования лёгких, как правило, составляет 10—40 мм. Полученные в результате исследования изображения демонстрируют характер структурных изменений в лёгких на основании данных на ограниченном участке (обычно 10 %).
В связи с тем, что зона сканирования при КТВР, как правило, меньше общей протяженности лёгких, метод нельзя использовать для диагностики рака лёгкого и другой локальной патологии. Также, в связи с высоким уровнем шума (связанным с тонкими срезами и высокоразрешающим алгоритмом реконструкции), невозможно достоверно визуализировать патологические изменения в мягких тканях средостения.
Литература
- Robin Smithuis, Otto van Delden and Cornelia Schaefer-Prokop. HRCT part I : Basic Interpretation. The Radiology Assistant. — Типичные симптомы поражения лёгочной ткани при КТВР-исследованиях (англ.). Дата обращения: 30 января 2012. Архивировано 28 марта 2012 года.